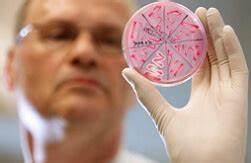

Диета кишечная инфекция ребенок
Картинка 2: Что такое кишечная инфекция у ребенка — причины, симптомы, лечение
Картинка 3: Отравление или кишечная инфекция: как отличить? Лекарства и препараты
Картинка 4: Кишечная инфекция: симптомы и лечение | Полисорб МП
Картинка 5: РОТОВИРУСНАЯ кишечная инфекция: симптомы и лечение у детей
Картинка 6: Кишечная инфекция у детей – симптомы
Картинка 7: Кишечная Инфекция Диета Для Детей — Похудение Диета Правильное Питание
Картинка 8: Инфекция ребенок беременность риск - Вопрос инфекционисту - 03 Онлайн
Картинка 9: Диета за чревна инфекция: как да храним дете, меню за възрастни и деца
Картинка 10: 5 тема. Апанасенко - Тема Возбудители дифтерии, коклюша, паракоклюша
Картинка 11: Кишечная инфекция - YouTube
Картинка 12: Кишечная Инфекция Диета Для Детей — Похудение Диета Правильное Питание
Картинка 13: Кишечная инфекция у детей как лечить – симптомы, признаки и лечение
Картинка 14: Кишечная инфекция: причины появления, симптомы и лечение у взрослых
Картинка 15: Профилактика острых кишечных инфекций - YouTube
Картинка 16: Диета при кишечной инфекции у детей меню и питание по доктору Комаровскому
Картинка 17: Кишечная инфекция у грудничка: признаки и профилактика
Картинка 18: Симптомы и лечение острой кишечной инфекции у детей в домашних условиях
Картинка 19: Кишечная инфекция: причины, первые признаки, симптомы и лечение
Картинка 20: Кишечная инфекция у детей – симптомы, лечение, диета, профилактика
Картинка 21: Кишечная инфекция - Презентация Медицина
Картинка 22: Болезнь Крона, кишечная микробиота и лечебная диета
Картинка 23: Кишечная инфекция – что это? - YouTube
Картинка 24: У детей кишечная инфекция: причины, виды и лечение
Картинка 25: Кишечная инфекция у взрослых - лечение, симптомы, диета, профилактика
Картинка 26: Кишечная инфекция – симптомы и лечение у детей, ротовирусная инфекция
Картинка 27: Кишечная инфекция – симптомы и лечение у детей, ротовирусная инфекция
Картинка 28: Пин на доске KZhhbsnnmkm Mmmllmmmmmmmkkklppp
Картинка 29: Кишечная Диета – Telegraph
Картинка 30: Диета 9 При Стероидном Диабете — Похудение Диета Правильное Питание
Картинка 31: [диета] ребенок диета после кишечной инфекции.
Картинка 32: Кишечная инфекция у ребенка - симптомы и неотложные меры - YouTube
Картинка 33: Результат. Ротавирусная инфекция, ребенок 1, 3 года. - YouTube
Картинка 34: Кишечная инфекция – причины, симптомы, диета и лечение в МЦ «Доктор
Картинка 35: Кишечная Диета – Telegraph
Картинка 36: Скачать презентацию Кишечная инфекция
Картинка 37: Купить Хвалить вулкан Жареная кишечная диета овощной фрукты и овощи
Картинка 38: Кишечная Инфекция У Ребенка 2 Года Диета — Похудение Диета Правильное
Картинка 39: Профилактика кишечных инфекций
Картинка 40: Врач назвал 5 опасных родительских ошибок при кишечной инфекции
Картинка 41: Кишечная инфекция - YouTube
Картинка 42: Кишечная Инфекция У Ребенка 2 Года Диета — Похудение Диета Правильное
Картинка 43: Кишечная Инфекция Диета Для Детей — Похудение Диета Правильное Питание
Картинка 44: Упражнения для похудения видео бесплатно, диета для мозгов, диета через
Картинка 45: Кишечная Инфекция У Ребенка 2 Года Диета — Похудение Диета Правильное
Картинка 46: Кишечная инфекция у взрослого: симптомы, лечение, профилактика
Картинка 47: Купить Хвалить вулкан Жареная кишечная диета овощной фрукты и овощи
Картинка 48: Кишечная инфекция – симптомы и лечение у детей, ротовирусная инфекция
Картинка 49: Кишечная Инфекция У Ребенка 2 Года Диета — Похудение Диета Правильное
Картинка 50: Кишечная Инфекция Диета Для Детей — Похудение Диета Правильное Питание
Картинка 51: Кишечная Инфекция У Ребенка 2 Года Диета — Похудение Диета Правильное
Картинка 52: Купить Хвалить вулкан Жареная кишечная диета овощной фрукты и овощи
Картинка 53: Кишечная Инфекция Диета Для Детей — Похудение Диета Правильное Питание
Картинка 54: Кишечная Инфекция Диета Для Детей — Похудение Диета Правильное Питание
Картинка 55: Кишечная Инфекция Диета Для Детей — Похудение Диета Правильное Питание
Картинка 56: Ротавирусная и кишечная инфекция у детей. Рекомендации по профилактике
Картинка 57: Кишечная Инфекция Диета Для Детей — Похудение Диета Правильное Питание
Картинка 58: Кишечная Инфекция Диета Для Детей — Похудение Диета Правильное Питание
Картинка 59: Кишечная Инфекция Диета Для Детей — Похудение Диета Правильное Питание
Картинка 60: Кишечная инфекция - Презентация Медицина

Диета после удаления селезенка

Диета и гв отзывы

Диета просто и вкусно

2 стадия сахарного диабета диет

Как похудеть найти стимул

Похудей упражнения гантели

Могут ли похудеть ноги от велотренажера

Список литературы о диете

Мясная диета при гастрите

Диета питания при болезнях печени

Кефирные диеты на 7 дней

Как убрать живот и бока в домашних условиях женщине после 30 лет отзывы

За месяц на 10кг как похудеть

Скачать самые эффективные диеты

Как похудеть за короткие сроки

Что будет если не есть после тренировки вечером чтобы похудеть

Как похудеть на 15 кг для подростков
Уберет ли бег бока

Похудеть с гербалайф за месяц

Тростниковый сахар на диете